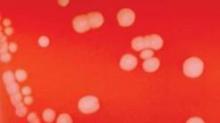

CDC okays group meningitis vaccination in emergency
FROM AN ACIP MEETING
Large-scale vaccination with a still-unapproved vaccine should be considered if multiple cases of serogroup B meningitis occur within 6 months in a community, a workgroup of the Centers for Disease Control and Prevention recommended June 26.
In groups of fewer than 5,000 people, vaccination should be considered if two or more cases present within 6 months. In larger communities, vaccination may be implemented if three or more cases present over 6 months, Jessica MacNeil said at a meeting of the CDC’s Advisory Committee on Immunization Practices.
The recommendation, which will be posted on the CDC’s meningitis web pages, was developed in response to last year’s group B meningitis outbreaks at the University of California, Santa Barbara, and at Princeton University, said Ms. MacNeil, an epidemiologist at the CDC and liaison with ACIP’s Meningococcal Outbreak Working Group.
When the outbreaks occurred, the CDC sponsored an expanded-access Investigational New Drug (IND) application so that students at both campuses could receive the unapproved vaccine.
The workgroup was convened in January and has conducted biweekly meetings to develop some interim guidance that would allow prompt response to future outbreaks in the absence of an approved vaccine.
"There are delays in getting a vaccination campaign in place under an IND," Ms. MacNeil said. "Therefore, we need to consider options early. We recognize that waiting for additional cases to occur before acting is difficult for organizations, so we need to have clear steps for each case already identified."
The proposed guideline begins with testing clinical specimens of Neisseria meningitides. Serogrouping should be initiated with 24 hours of collection. Labs that can’t do so within 72 hours need to transfer the specimen to a lab that can or get samples to the CDC within 24 hours.
The CDC will work with state and local health departments in determining whether or not a large-scale vaccination is appropriate. That decision involves several considerations: the number of cases, the size of the community involved, the strains present in the cases, the feasibility and cost of vaccinating, and vaccine availability.
For groups of fewer than 5,000, one case of meningitis should activate routine public health practices: serogrouping, a case investigation, and chemoprophylaxis for close contacts. The isolates should be saved.
Once two or more cases have been identified, specimens should be sent to the CDC for molecular genotyping. If they are identified as serogroup B and, thus, likely to be covered by the MenB vaccine, local health officials may consult with CDC about using the vaccine under the expanded access IND program.
In communities of 5,000 or more, a single case will prompt the same routine public health practices. If two cases occur within 6 months, the isolates should be tested. If they are both serogroup B, the CDC should be notified and the situation carefully monitored. If three or more cases develop and the isolates are all serogroup B, then the IND vaccination campaign can be considered.
If the CDC-sponsored IND is activated, any organization that provides the vaccine must appoint a local coinvestigator. The group will be required to participate in safety follow-up studies as required by the program.
Ms. MacNeil added that the universities that have implemented MenB vaccination campaigns are bearing the cost of obtaining and administering the vaccine.
She also discussed the value of large-scale chemoprophylaxis. A literature review identified 18 instances in which mass chemoprophylaxis had been used as an outbreak response. These suggested that chemoprophylaxis resulted in decreases in carriage soon after, but no permanent clearance.
"Mass chemoprophylaxis is not recommended as a stand-alone measure to control outbreaks of meningococcal disease," she said. "It may be considered as an interim measure to reduce carriage and transmission in the period before potential protection from vaccination can be achieved."
However, she added, chemoprophylaxis only would be effective in small or closed populations with limited mixing from the outside – like jails or residential facilities.
"It would be difficult to ensure that everyone in the target group could receive treatment within a short time frame," she said. And dosing everyone in a population opens up the possibility of idiosyncratic adverse reactions and interactions with other commonly used medications, including antidepressants.
"In many outbreak settings, particularly when a small, closed, at-risk population can’t be defined, the disadvantages outweigh the possible benefits," she said.
She said the guidance will be published within a few days on the CDC’s meningitis pages.